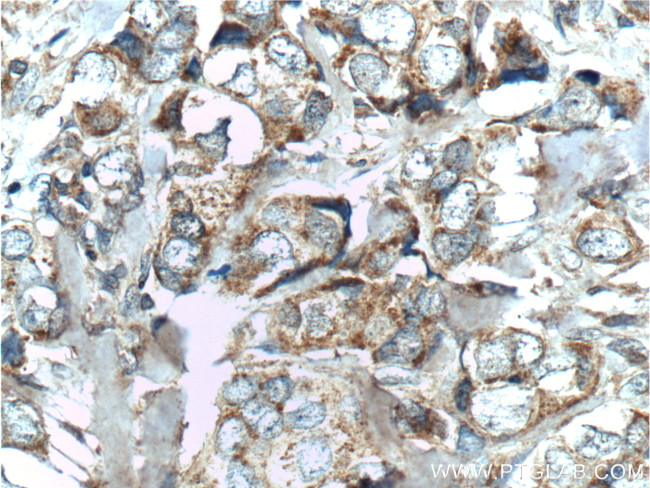
hCG beta Antibody in Immunohistochemistry (Paraffin) (IHC (P))

Search
Proteintech
hCG beta Polyclonal Antibody
{{$productOrderCtrl.translations['antibody.pdp.commerceCard.promotion.promotions']}}
{{$productOrderCtrl.translations['antibody.pdp.commerceCard.promotion.viewpromo']}}
{{$productOrderCtrl.translations['antibody.pdp.commerceCard.promotion.promocode']}}: {{promo.promoCode}} {{promo.promoTitle}} {{promo.promoDescription}}. {{$productOrderCtrl.translations['antibody.pdp.commerceCard.promotion.learnmore']}}
产品信息
11615-1-AP
种属反应
已发表种属
宿主/亚型
分类
类型
抗原
偶联物
形式
浓度
规格
纯化类型
保存液
内含物
保存条件
运输条件
产品详细信息
Immunogen sequence: MEMFQGLLL LLLLSMGGTW ASKEPLRPRC RPINATLAVE KEGCPVCITV NTTICAGYCP TMTRVLQGVL PALPQVVCNY RDVRFESIRL PGCPRGVNPV VSYAVALSCQ CALCRRSTTD CGGPKDHPLT CDDPRFQDSS SSKAPPPSLP SPSRLPGPSD TPILPQ (1-165 aa encoded by B C022796)
靶标信息
hCG beta is the beta chain of hCG (Human chorionic gonadotropin), a 40 kDa glycoprotein hormone produced by trophoblastic cells of the placenta beginning 10 to 12 days after conception. hCG is made up of alpha and beta subunits that are non-covalently associated. The alpha subunit is similar to those found on the pituitary hormones FSH, LH ans TSH. However, the beta subunit is different in FSH, LH and TSH and are involved in conferring biological specificity. Maintenance of the fetus in the first trimester of pregnancy requires the production of hCG, which binds to the corpus luteum of the ovary which is stimulated to produce progesterone which in turn maintains the secretory endometrium. hCG is present only in trace amounts in non-pregnant urine and sera but rises sharply during pregnancy. HCG is composed of two non-identical, non-covalently linked polypeptide chains designated as the alpha and Beta subunits. The alpha subunit is identical to that of thyroid stimulating hormone (TSH), follicle stimulating hormone (FSH), and luteinizing hormone (LH). Diseases associated with Hcg dysfunction include gestational trophoblastic tumor and hydatidiform mole, recurrent 1.
仅用于科研。不用于诊断过程。未经明确授权不得转售。
生物信息学
蛋白别名: CG-beta; Choriogonadotropin subunit beta; Choriogonadotropin subunit beta 3; chorionic gonadotrophin chain beta; chorionic gonadotropin beta 3 subunit; chorionic gonadotropin beta chain; chorionic gonadotropin beta subunit 3; Chorionic gonadotropin chain beta; chorionic gonadotropin human; chorionic gonadotropin, beta polypeptide; FSH-alpha; human chorionic gonadotropin; LSH-alpha; luteinizing hormone beta subunit; TSH-alpha; unnamed protein product
基因别名: CGB; CGB3; CGB5; CGB7; CGB8; hCGB; LHB
UniProt ID: (Human) P0DN86
Entrez Gene ID: (Human) 1082